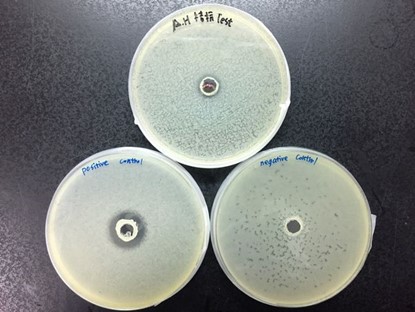

硝化+抗菌 - 新概念硝化菌產品
養魚的過程中,難免會碰到魚病的問題,魚不會喊痛喊累,當飼主發現病徵時,往往已經病入膏肓,回天乏術,到底魚為什麼那麼容易生病,亦或為何疾病難以根治,有時根本的原因反而不在疾病本身
水生生物之所以會被病原菌感染,都與感染三要素有關,分別是宿主狀態、病原濃度、以及生活環境

因此要降低感病風險,就要從此三項要素著手,設法提高宿主免疫力(使用飼料添加劑),降低病原密度(添加殺菌劑/抗病原益生菌),或改善養殖環境(建立完整硝化系統),不過這三項要素往往是互相連動的,例如環境不佳造成免疫力下降及病原菌孳生,生物體因此被病菌趁虛而入,因此在健康管理上,也必須就綜合層面來考慮
而如何能讓硝化菌產品在有效處理水質的基礎上,附加降低疾病感染風險之功能呢? 在與水試所合作之中,似乎發現了新方法
由水試所技轉之抗菌益生菌Bacillus pumilus D5,實驗證實能降低養殖環境及水族生物中的弧菌、產氣單孢菌、鏈球菌等病原菌含量,進而有效預防及抑制多種疾病

利用原本的硝化菌來改善水質+添加D5降低病源量+引入魚源乳酸菌刺激魚蝦非特異性免疫,三項配合,對應傳染病的三大要素,不僅能改善環境,還能降低感病風險,水色職人系列因而誕生,可謂水族界之創舉,唯一缺點是為了保持純菌活性,系列產品需要冷藏以長期保存(短時間的運輸可不需要)
益生菌雖然有許多優點,但他並非萬能,使用益生菌要有預防勝於治療的概念,亦無法取代打氣換水、清潔殺菌及生病用藥的流程,但能作為環境控制及健康管理上的輔助,不論是環境控制型或是增加產量型益生菌,產品種類皆相當多樣,除了要慎選產品之外,也要了解用法,才能收到應有的效果
B. pumilus D5能拮抗淡水產氣單孢菌(上)、海洋弧菌(左),但與其他益生菌不會有衝突(右)
